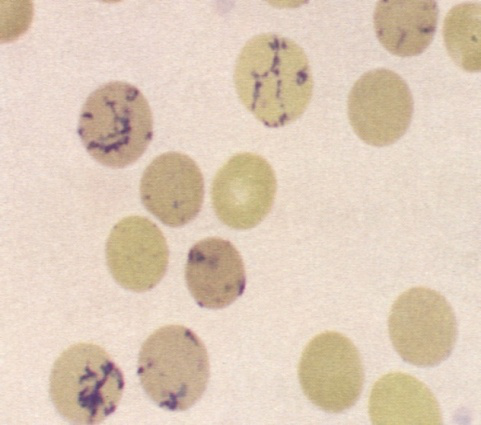

网织红细胞计数
更新时间: 点击:9774 所属栏目:经验分享 Update Time: Hits:9774 Belong Column:1. 什么是网织红细胞?
网织红细胞(reticulocyte,Ret,RET)是介于晚幼红细胞和成熟红细胞之间的过渡细胞,略大于成熟红细胞(直径8.0~9.5 微米),其胞质中残存的嗜碱性物质RNA经碱性染料(如煌焦油蓝、新亚甲蓝等)活体染色后,形成蓝色或紫色的点粒状或丝网状沉淀物。网织红细胞自骨髓释放到外周血液后仍具有合成血红蛋白的能力,约1~2天后,过渡为成熟红细胞。
成熟红与网织红细胞形态
2. 为什么要检测网织红细胞?
网织红细胞的检测目的:
① 鉴别贫血的类型(增生性、非增生性、增生增高性)。
② 检查骨髓的功能。
③ 检测贫血的治疗效果。
④ 评估骨髓移植后、再生障碍性贫血细胞毒药物透导治疗后或EPO(促红素)治疗后的红细胞造血情况。
3. SYSMEX仪器RET检测通道
⑴ 检测原理:使用半导体激光的核酸荧光染色流式细胞术。
⑵ 检测项目:RET%、 RET#、RET-HE


RET散点图
4. 临床意义
网织红细胞计数是反映骨髓造血功能的重要指标。
⑴ 评价骨髓增生能力,判断贫血类型
a. 网织红细胞增多:表示骨髓造血功能旺盛,见于各种增生性贫血,溶血性贫血增多尤为显著。
b. 网织红细胞减少:是无效红细胞造血的指征,见于非增生性贫血(如铁、铜、维生素B6、维生素B12缺乏)、慢性病性贫血(如慢性炎症、恶性肿瘤、慢性肾衰竭、再生障碍性贫血等)。
c. 鉴别贫血:
① 小细胞性贫血:当铁蛋白和转铁蛋白饱和度正常时,网织红细胞增多常见于血红蛋白病,网织红细胞正常常见于慢性炎症性疾病。
② 正细胞性贫血:网织红细胞增多常见于急性出血和溶血综合征,网织红细胞正常或降低常见于骨髓衰竭或慢性贫血。
③ 大细胞性贫血:网织红细胞增多常提示用维生素B12或叶酸治疗。
⑵ 评价疗效
a. 观察贫血疗效:网织红细胞是贫血患者随访检查的项目之一。缺铁性贫血或巨幼细胞性贫血经有效治疗2~3天后,网织红细胞开始上升,7~10天达到最高峰(约10%),2周后逐渐降至正常水平。
b. 骨髓移植后检测骨髓造血恢复:骨髓移植后第21天,如网织红细胞>15×109/L,常表示无移植并发症;若骨髓开始恢复造血功能,首先表现为HFR 和MFR 的升高,其次为网织红细胞升高。因此RMI 的改变更为灵敏。
⑶ 放疗和化疗的监测 网织红细胞的动态观察可指导临床适时调整治疗方案,避免造成严重的骨髓抑制。机体接受放疗、化疗后,如出现骨髓抑制,早期HFR 和MFR 降低,而后网织红细胞降低;停止治疗,骨髓功能恢复后,就这些指标逐渐恢复。
⑷ 药物影响许多药物可引起外周血液网织红细胞变化,可导致网织红细胞假阳性的药物有解热药、氯喹、左旋多巴、奎宁等;可导致网织红细胞假阴性的有硫唑嘌呤、氯霉素、甲氨喋呤等。网织红细胞的效应药物:a Ret>1.5%:铁剂、维生素B12和叶酸。b Ret<0.5%:硫唑嘌呤、氯霉素、卡马西平。
技术部 李娜 供稿


